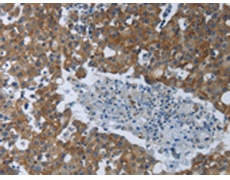
一抗

|
Background: |
The protein encoded by this gene is a serine/threonine protein kinase that is activated by autophosphorylation after binding to dsRNA. The activated form of the encoded protein can phosphorylate translation initiation factor EIF2S1, which in turn inhibits protein synthesis. This protein is also activated by manganese ions and heparin. Three transcript variants encoding two different isoforms have been found for this gene |
|
Applications: |
ELISA, IHC |
|
Name of antibody: |
EIF2AK2 |
|
Immunogen: |
Synthetic peptide of human EIF2AK2 |
|
Full name: |
Eukaryotic translation initiation factor 2-alpha kinase 2 |
|
Synonyms: |
PKR, PRKR, EIF2AK1 |
|
SwissProt: |
P19525 |
|
ELISA Recommended dilution: |
2000-10000 |
|
IHC positive control: |
Human breast cancer |
|
IHC Recommend dilution: |
50-200 |

 購(gòu)物車
購(gòu)物車 幫助
幫助
 021-54845833/15800441009
021-54845833/15800441009